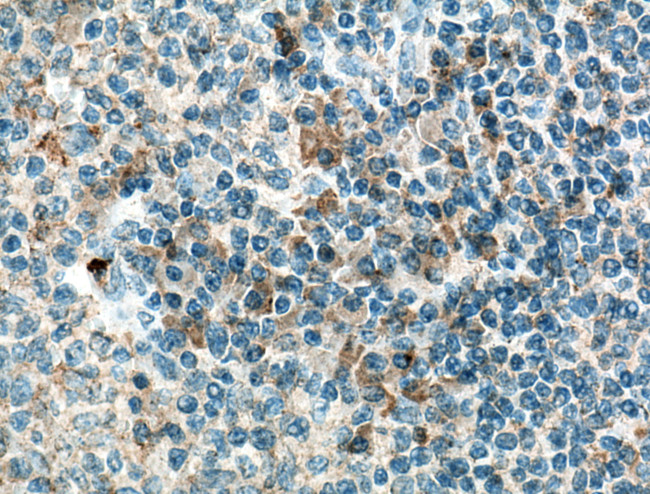
IL36 beta/IL1F8 Antibody in Immunohistochemistry (Paraffin) (IHC (P))

Search
Proteintech
IL36 beta/IL1F8 Monoclonal Antibody (10D12B1)
{{$productOrderCtrl.translations['antibody.pdp.commerceCard.promotion.promotions']}}
{{$productOrderCtrl.translations['antibody.pdp.commerceCard.promotion.viewpromo']}}
{{$productOrderCtrl.translations['antibody.pdp.commerceCard.promotion.promocode']}}: {{promo.promoCode}} {{promo.promoTitle}} {{promo.promoDescription}}. {{$productOrderCtrl.translations['antibody.pdp.commerceCard.promotion.learnmore']}}
产品信息
60290-1-IG
种属反应
宿主/亚型
分类
类型
克隆号
抗原
偶联物
形式
浓度
规格
纯化类型
保存液
内含物
保存条件
运输条件
产品详细信息
Immunogen sequence: MNPQREAAP KSYAIRDSRQ MVWVLSGNSL IAAPLSRSIK PVTLHLIACR DTEFSDKEKG NMVYLGIKGK DLCLFCAEIQ GKPTLQLKEK NIMDLYVEKK AQKPFLFFHN KEGSTSVFQS VSYPGWFIAT STTSGQPIFL TKERGITNNT NFYLDSVE (1-157 aa encoded by BC101833)
靶标信息
IL-36B is is a member of the interleukin 1 cytokine family whose gene and eight other interleukin 1 family genes form a cytokine gene cluster on chromosome 2. IL-36B is thought to activate the NF-kappaB pathway through IL-1 receptor family members IL-1RL2 and IL-1RAcP. Like the related proteins IL-36A and IL-36G, IL-36B requires post-translational processing for full agonist activity, but the cleavage mechanism is currently unknown. The IL-36 cytokines have been suggested to amplify Th1 responses by enhancing proliferation and Th1 polarization of naive CD4+ T cells.
仅用于科研。不用于诊断过程。未经明确授权不得转售。
篇参考文献 (0)
生物信息学
蛋白别名: cytokine; hIL-1H2; family of interleukin 1-eta; FIL1 eta; IL-1 eta; IL-1F8; IL-1F8 (FIL1-eta); IL-1H2; Interleukin; interleukin 1 family, member 8 (eta); Interleukin-1 eta; Interleukin-1 family member 8; Interleukin-1 homolog 2; Interleukin-1 Superfamily e; Interleukin-36 beta; similar to IL-1
基因别名: FIL1; FIL1-(ETA); FIL1H; FILI-(ETA); IL-1F8; IL-1H2; IL1-ETA; IL1F8; IL1H2; IL36B
UniProt ID: (Human) Q9NZH7
Entrez Gene ID: (Human) 27177